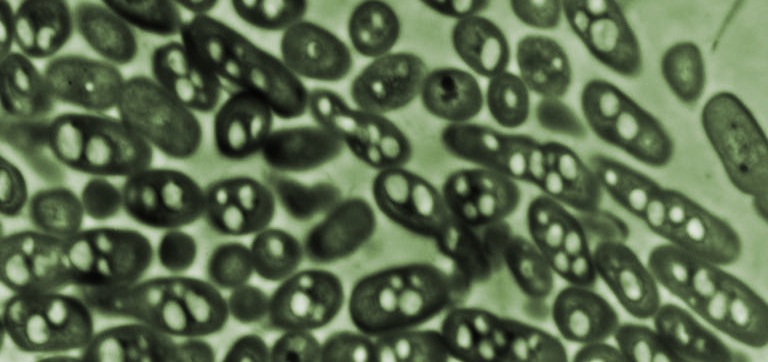

July 31, 2013
News Release

(From
left) Eli Yablonovitch, Ali Javey and Hui Fang discovered a simple law
of light absorption for 2D semiconductors that should open doors to
exotic new optoelectronic and photonic technologies. (Photo by Roy
Kaltschmidt)
Working with ultrathin membranes of the semiconductor indium arsenide, a team of researchers with the U.S. Department of Energy (DOE)’s Lawrence Berkeley National Laboratory (Berkeley Lab) has discovered a quantum unit of photon absorption, which they have dubbed “AQ,” that should be general to all 2D semiconductors, including compound semiconductors of the III-V family that are favored for solar films and optoelectronic devices. This discovery not only provides new insight into the optical properties of 2D semiconductors and quantum wells, it should also open doors to exotic new optoelectronic and photonic technologies.
“We used free-standing indium arsenide membranes down to three nanometers in thickness as a model material system to accurately probe the absorption properties of 2D semiconductors as a function of membrane thickness and electron band structure,” says Ali Javey, a faculty scientist in Berkeley Lab’s Materials Sciences Division and a professor of electrical engineering and computer science at the University of California (UC) Berkeley. “We discovered that the magnitude of step-wise absorptance in these materials is independent of thickness and band structure details.”

Indium
arsenide is a III–V semiconductor with electron mobility and velocity
that make it an outstanding candidate for future high-speed, low-power
opto-electronic devices.
Previous work has shown that graphene, a two-dimensional sheet of carbon, has a universal value of light absorption. Javey, Yablonovitch and their colleagues have now found that a similar generalized law applies to all 2D semiconductors. This discovery was made possible by a unique process that Javey and his research group developed in which thin films of indium arsenide are transferred onto an optically transparent substrate, in this case calcium fluoride.
“This provided us with ultrathin membranes of indium arsenide, only a few unit cells in thickness, that absorb light on a substrate that absorbed no light,” Javey says. “We were then able to investigate the optical absorption properties of membranes that ranged in thickness from three to 19 nanometers as a function of band structure and thickness.”

In
this FTIR microspectroscopy study, light absorption spectra are
obtained from measured transmission and reflection spectra in which the
incident light angle is perpendicular to the membrane.
“This absorption law appears to be universal for all 2D semiconductor systems,” says Yablonovitch. “Our results add to the basic understanding of electron–photon interactions under strong quantum confinement and provide a unique insight toward the use of 2D semiconductors for novel photonic and optoelectronic applications.”
This research was supported by DOE’s Office of Science and the National Science Foundation.
# # #
Lawrence Berkeley National Laboratory addresses the world’s most
urgent scientific challenges by advancing sustainable energy, protecting
human health, creating new materials, and revealing the origin and fate
of the universe. Founded in 1931, Berkeley Lab’s scientific expertise
has been recognized with 13 Nobel prizes. The University of California
manages Berkeley Lab for the U.S. Department of Energy’s Office of
Science. For more, visit www.lbl.gov.The DOE Office of Science is the single largest supporter of basic research in the physical sciences in the United States and is working to address some of the most pressing challenges of our time. For more information, please visit science.energy.gov.
The Advanced Light Source is a third-generation synchrotron light source producing light in the x-ray region of the spectrum that is a billion times brighter than the sun. A DOE national user facility, the ALS attracts scientists from around the world and supports its users in doing outstanding science in a safe environment. For more information visit www-als.lbl.gov/.The Advanced Light Source is a third-generation synchrotron light source producing light in the x-ray region of the spectrum that is a billion times brighter than the sun. A DOE national user facility, the ALS attracts scientists from around the world and supports its users in doing outstanding science in a safe environment. For more information visit http://www.als.lbl.gov/.